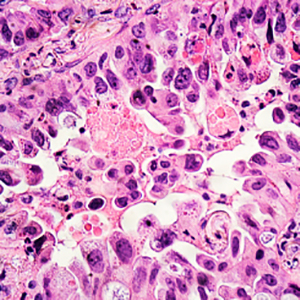

Inflammatory response in human lung cells stimulated with plasma from COPD patients
Keywords:
COPD, inflammation, MMP-9, IL-8, CRPAbstract
Background: Chronic obstructive pulmonary disease (COPD) is a condition resulting from a persistent inflammatory state in the airways even after smoking cessation. Intriguingly, the reasons behind this persistence of the inflammatory influx without smoking exposure have not been fully unraveled. We aimed to explore the hypothesis that systemic inflammation in COPD patients influences lung cell inflammatory response.
Methods: We cultured human lung fibroblast and human airway epithelial cell lines with plasma from COPD patients (four emphysematous-COPD, four asthma-COPD overlap, four chronic bronchitis-COPD, and four bronchiectasis-COPD), and four smokers or ex-smokers without COPD as controls. We measured Interleukine-8 (IL-8), C-reactive protein (CRP) and matrix metalloproteinase-9 (MMP-9) in plasma and culture supernatants by ELISA.
Results: Cells stimulated with plasma from COPD patients and control subjects produced higher CRP, IL-8 and MMP-9 levels, an increase for COPD in CRP(p=0.039) in epithelial cells and IL-8(p=0.039) in fibroblasts and decrease for MMP-9(p=0.039) in fibroblasts. The response was higher in epithelial cells for IL-8(p=0.003) and in fibroblasts for MMP-9(p=0.063). The plasma from chronic bronchitis and bronchiectasis phenotypes induced higher IL-8 in fibroblasts.
Conclusions: Plasma from COPD patients increases the inflammatory response in lung epithelial cells and lung fibroblasts, with a different response depending on the cell type and clinical phenotype.
References
Schols AM, Slangen J, Volovics L, Wouters EF. Weight loss is a reversible factor in the prognosis of chronic obstructive pulmonary disease. Am J Respir Crit Care Med 1998;157:1791-7.
Garcia-Rio F, Miravitlles M, Soriano JB, Munoz L, Duran-Tauleria E, Sanchez G, et al Systemic inflammation in chronic obstructive pulmonary disease: a population-based study. Respir Res 2010;11:63.
Mannino DM, Ford ES, Redd SC. Obstructive and restrictive lung disease and markers of inflammation: data from the Third National Health and Nutrition Examination. Am J Med 2003;114:758-62.
Dahl M, Tybjaerg-Hansen A, Vestbo J, Lange P, Nordestgaard BG. Elevated plasma fibrinogen associated with reduced pulmonary function and increased risk of chronic obstructive pulmonary disease. Am J Respir Crit Care Med 2001;164:1008-11.
Rahman I, Morrison D, Donaldson K, MacNee W. Systemic oxidative stress in asthma, COPD, and smokers. Am J Respir Crit Care Med 1996;154:1055-1060.
Thomsen M, Dahl M, Lange P, Vestbo J, Nordestgaard BG. Inflammatory biomarkers and comorbidities in chronic obstructive pulmonary disease. Am J Respir Crit Care Med 2012;186:982-8.
Ferrari R, Tanni SE, Caram LM, Correa C, Correa CR, Godoy I. Three-year follow-up of Interleukin 6 and C-reactive protein in chronic obstructive pulmonary disease. Respir Res 2013;14:24.
Su B, Liu T, Fan H, Chen F, Ding H, Wu Z, et al. Inflammatory markers and the risk of chronic obstructive pulmonary disease: A Systematic review and meta-analysis. PLoS One 2016;11:e0150586.
Calero C, Arellano E, Lopez-Villalobos JL, Sanchez-Lopez V, Moreno-Mata N, Lopez-Campos JL. Differential expression of C-reactive protein and serum amyloid A in different cell types in the lung tissue of chronic obstructive pulmonary disease patients. BMC Pulm Med 2014;14:95.
Lopez-Campos JL, Calero C, Rojano B, Lopez-Porras M, Saenz-Coronilla J, Blanco AI, et al. C-reactive protein and serum amyloid a overexpression in lung tissues of chronic obstructive pulmonary disease patients: a case-control study. Int J Med Sci 2013;10:938-47.
Wouters EF, Reynaert NL, Dentener MA, Vernooy JH. Systemic and local inflammation in asthma and chronic obstructive pulmonary disease: is there a connection? Proc Am Thorac Soc 2009;6:638-47.
Gamble E, Grootendorst DC, Hattotuwa K, O'Shaughnessy T, Ram FS, Qiu Y, et al. Airway mucosal inflammation in COPD is similar in smokers and ex-smokers: a pooled analysis. Eur Respir J 2007;30:467-471.
Turato G, Di Stefano A, Maestrelli P, Mapp CE, Ruggieri MP, Roggeri A, et al. Effect of smoking cessation on airway inflammation in chronic bronchitis. Am J Respir Crit Care Med 1995;152:1262-7.
Rutgers SR, Postma DS, ten Hacken NH, Kauffman HF, van Der Mark TW, Koeter GH, et al. Ongoing airway inflammation in patients with COPD who do not currently smoke. Thorax 2000;55:12-8.
Miravitlles M, Soler-Cataluna JJ, Calle M, Molina J, Almagro P, Quintano JA, et al. Spanish COPD Guidelines (GesEPOC): pharmacological treatment of stable COPD. Spanish Society of Pulmonology and Thoracic Surgery. Arch Bronconeumol 2012;48:247-57.
Miravitlles M, Soler-Cataluna JJ, Calle M, Molina J, Almagro P, Quintano JA, et al. Spanish Guidelines for management of chronic obstructive pulmonary disease (GesEPOC) 2017. Pharmacological treatment of stable phase. Arch Bronconeumol 2017, 53:324-335.
Kapellos TS, Bassler K, Aschenbrenner AC, Fujii W, Schultze JL. Dysregulated Functions of Lung Macrophage Populations in COPD. J Immunol Res 2018;2018:2349045.
Hancox RJ, Gray AR, Sears MR, Poulton R. Systemic inflammation and lung function: A longitudinal analysis. Respir Med 2016;111:54-59.
Li Y, Lu Y, Zhao Z, Wang J, Li J, Wang W, et al. Relationships of MMP-9 and TIMP-1 proteins with chronic obstructive pulmonary disease risk: A systematic review and meta-analysis. J Res Med Sci 2016;21:12.
Lapperre TS, Postma DS, Gosman MM, Snoeck-Stroband JB, ten Hacken NH, Hiemstra PS, et al. Relation between duration of smoking cessation and bronchial inflammation in COPD. Thorax 2006;61:115-21.
Li QY, Huang SG, Wan HY, Wu HC, Zhou T, Li M, et al. Effect of smoking cessation on airway inflammation of rats with chronic bronchitis. Chin Med J (Engl) 2007;120:1511-6.
Kunz LI, Lapperre TS, Snoeck-Stroband JB, Budulac SE, Timens W, van Wijngaarden S, et al. Smoking status and anti-inflammatory macrophages in bronchoalveolar lavage and induced sputum in COPD. Respir Res 2011;12:34.
Wen L, Krauss-Etschmann S, Petersen F, Yu X. Autoantibodies in chronic obstructive pulmonary disease. Front Immunol 2018;9:66.
Cho WK, Lee CG, Kim LK. COPD as a disease of immunosenescence. Yonsei Med J 2019;60:407-13.
Tan WC, Sin DD, Bourbeau J, Hernandez P, Chapman KR, Cowie R, et al. Characteristics of COPD in never-smokers and ever-smokers in the general population: results from the CanCOLD study. Thorax 2015;70:822-9.
Higashimoto Y, Yamagata Y, Taya S, Iwata T, Okada M, Ishiguchi T, et al. Systemic inflammation in chronic obstructive pulmonary disease and asthma: Similarities and differences. Respirology 2008, 13:128-133.
Gan WQ, Man SF, Senthilselvan A, Sin DD. Association between chronic obstructive pulmonary disease and systemic inflammation: a systematic review and a meta-analysis. Thorax 2004;59:574-80.
Lim SY, Zhao D, Guallar E, Chang Y, Ryu S, Cho J, et al. Risk of chronic obstructive pulmonary disease in healthy individuals with high C-reactive protein levels by smoking status: a population-based cohort study in Korea. Int J Chron Obstruct Pulmon Dis 2019;14:2037-46.
Gorska K, Krenke R, Kosciuch J, Korczynski P, Zukowska M, Domagala-Kulawik J, et al. Relationship between airway inflammation and remodeling in patients with asthma and chronic obstructive pulmonary disease. Eur J Med Res 2009;14:S90-6.
Nowrin K, Sohal SS, Peterson G, Patel R, Walters EH. Epithelial-mesenchymal transition as a fundamental underlying pathogenic process in COPD airways: fibrosis, remodeling and cancer. Expert Rev Respir Med 2014;8:547-59.
Singh D, Srivastava SK, Chaudhuri TK, Upadhyay G. Multifaceted role of matrix metalloproteinases (MMPs). Front Mol Biosci 2015;2:19.
Lemjabbar H, Gosset P, Lamblin C, Tillie I, Hartmann D, Wallaert B, et al. Contribution of 92 kDa gelatinase/type IV collagenase in bronchial inflammation during status asthmaticus. Am J Respir Crit Care Med 1999;159:1298-307.
Han MK, Agusti A, Calverley PM, Celli BR, Criner G, Curtis JL, et al. Chronic obstructive pulmonary disease phenotypes: the future of COPD. Am J Respir Crit Care Med 2010;182:598-604.
Petersen H, Vazquez Guillamet R, Meek P, Sood A, Tesfaigzi Y. Early endotyping: A chance for intervention in chronic obstructive pulmonary disease. Am J Respir Cell Mol Biol 2018;59:13-7.
Atkinson JJ, Lutey BA, Suzuki Y, Toennies HM, Kelley DG, Kobayashi DK, et al. The role of matrix metalloproteinase-9 in cigarette smoke-induced emphysema. Am J Respir Crit Care Med 2011;183:876-84.
Koo HK, Hong Y, Lim MN, Yim JJ, Kim WJ. Relationship between plasma matrix metalloproteinase levels, pulmonary function, bronchodilator response, and emphysema severity. Int J Chron Obstruct Pulmon Dis 2016;11:1129-37.
Barnes PJ. Inflammatory endotypes in COPD. Allergy 2019;74:1249-56.
Reddel HK, Gerhardsson de Verdier M, Agusti A, Anderson G, Beasley R, Bel EH, et al. Prospective observational study in patients with obstructive lung disease: NOVELTY design. ERJ Open Res 2019;5:00036-2018.
Downloads
Published
Issue
Section
License
Copyright (c) 2022 The Author(s)

This work is licensed under a Creative Commons Attribution-NonCommercial 4.0 International License.
Mattioli 1885 has chosen to apply the Creative Commons Attribution NonCommercial 4.0 International License (CC BY-NC 4.0) to all manuscripts to be published.




